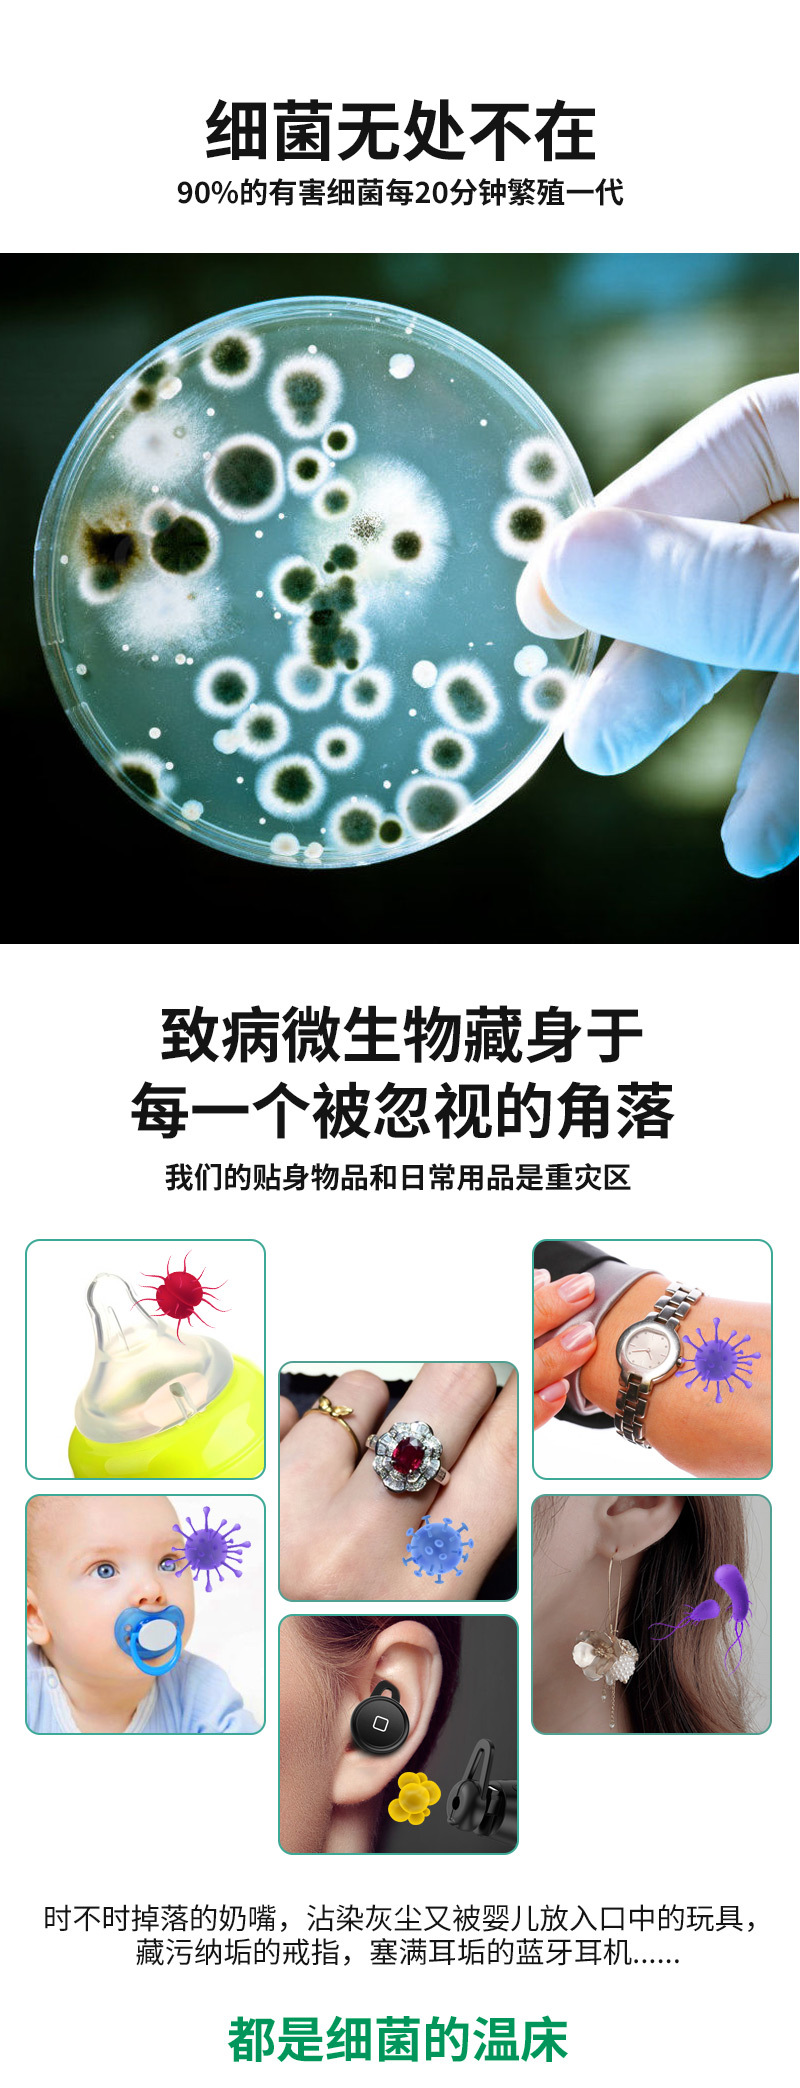
1688_03.jpg

| QTY |
| FOB PRICE |
CIF PRICE
QUANTITY
-
+
PCS
TOTAL COST
$1660| Product category : Nipple sterilizer,lampda,White,Light blue,Pink,ABS,Built-in rechargeable lithium battery,Open/close cover,Ultraviolet Disinfection,Yes,Creative Style,Integrated,NBD-NS01,Ultraviolet Disinfection,Table type,More than 30 days,500mAh-800mAh (included),Built-in battery |
| Material : Default |
| Pcs/Carton : N/A | Packing Size/Carton : N/A | Packing Vol/Carton : N/A |
| N.W./Carton : N/A | G.W./Carton : N/A | QTY in 40HQ : N/A |
| QTY in 40GP : N/A | QTY in 20GP : N/A |

深圳市能波达光电科技有限公司,位于深圳市龙岗区宝龙工业城高新技术园区。能波达一直致力于特种光源紫外线灯管的应用研发与生产。是一家专业从事冷阴极紫外线杀菌灯管及驱动的开发、制造与销售为一体的高新技术企业。目前已量产UV杀菌水壶、奶瓶奶嘴杀菌器、壁挂式牙刷消毒器、手机消毒盒、便携式牙刷消毒器、除螨仪中的杀菌方案。
公司拥有20年紫外线灯管应用及驱动电源开发方案经验的专业技术团队;拥有专业的实验室、测试室,自动化、半自动化生产设备多条,实现了现代化、标准化、规模化生产,严格控制品质保障,确保产品稳定、可靠,公司于2014年通过ISO14001:环境管理体系认证证书,符合GB/T24001-2004 idt ISO14001:2004标准。目前系列产品已通过CE、RoHS、PSE等认证。
公司自成立以来,能波达人秉承"诚信、实效、完美、创新、超越”的经营管理理念,雄厚的技术力量和开发能力,先进的生产设备和高素质的管理人员加上训练有素的员工队伍,确保我们所有产品都具有优良的品质,并随时为客户提供高品质,优质服务的产品。未来,能波达还将引进大批专业人才和先进设备,不断优化、持续创新,进一步提升产品性能、保证产品质量、开发高端产品,以客户满意为己任,不断进步,为健康的生活空间和绿色的生态环境发挥最大的能量。


• Amanbo Return Policy applies to all orders on amanbo.com.
• If products are not as described, returns are accepted and return shipping fee should be paid by buyer.
• If products are as described, seller has the right to refuse return. Buyer should pay return shipping fee if return require is insisted on.